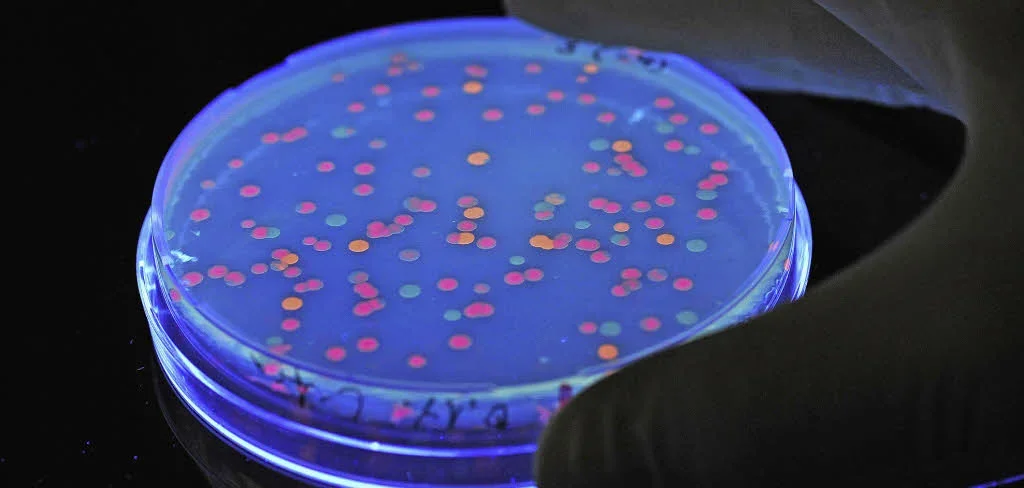

De mikroskopiske reisfølgene, kjent som reisebakterier, kan forårsake alvorlige helseproblemer for de som er utsatt for dem, uansett om man reiser til et tropisk paradis eller en europeisk by.
Disse stadig mer synlige, farlige mikrober kan overføres gjennom mat og vann, og de stiller store utfordringer for den reisende som ønsker å oppleve den ytre verden uten å bli syk.
Å forstå disse reisebakteriene er avgjørende for å beskytte helsen og nyte reisen uten uønskede bivirkninger. Ulike typer reisebakterier har forskjellige overføringsmekanismer og krever dermed tilpassede strategier for å unngå infeksjon.
Disse bakteriene, som kan finnes i mat og vann, kan forårsake alt fra lett mage-tarmlidelser til mer alvorlige lidelser som krever medisinsk behandling.
Riktig hygiene og kunnskap om matsikkerhet er derfor helt avgjørende for en trygg reiseopplevelse. Ved å være oppmerksom på risikoen og følge noen enkle råd, kan du redusere risikoen for å bli utsatt for disse skadelige reisebakteriene.
Mye tyder på at reisebakterier er et økende problem, spesielt i forbindelse med økt internasjonal reiseaktivitet. Hvert år rammes millioner av mennesker av gastrointestinale lidelser på grunn av forurenset mat eller drikke.
I denne artikkelen vil vi utforske hvordan disse reisebakteriene overføres, hvilke symptomer de forårsaker, og hva du kan gjøre for å beskytte deg selv. Kunnskap om ulike typer reisebakterier og deres spesifikke egenskaper er sentralt i strategien for å forebygge infeksjoner på reisen.
Ved å forstå disse små, men potensielt farlige reisebakteriene, kan du ta velinformerte valg om mat og drikke under dine reiser, og slik sikre en mer behagelig og trygg opplevelse. Ved å følge disse rådene kan man betydelig redusere risikoen for å oppleve ubehagelige konsekvenser av reisebakterier.
Reisebakteriers betydning for reiser og helse
Reisebakterier representerer en betydelig utfordring for reisende som ønsker å utforske verden uten å bli syke.
Disse mikroskopiske organismene kan forårsake en rekke ubehagelige symptomer, fra milde mageproblemer til alvorlige sykdommer som krever medisinsk behandling.
Forskjellige typer reisebakterier har unike egenskaper og krever forskjellige tilpasninger for å unngå infeksjon.
Kjennskap til disse reisebakteriene er avgjørende for å kunne beskytte seg mot sykdommer under reiser, og for å vite hvordan man bør tilpasse kosthold og hygiene.
Overføring av reisebakterier skjer ofte gjennom forurenset mat eller drikkevann, noe som gjør det ekstra viktig å være oppmerksom på hygieniske forhold på reise.
Ved å forstå de ulike mekanismene for spredning av reisebakterier, kan reisende redusere risikoen for å bli smittet, og dermed nyte reisen uten helseproblemer.
Faktorer som mattemperatur, forberedelse av mat, og hygieniske forhold på reisemål spiller alle en viktig rolle for å unngå infeksjon med reisebakterier.
Det finnes en rekke effektive tiltak man kan iverksette for å beskytte seg mot reisebakterier, inkludert å være oppmerksom på hygiene, velge sikre matvalg, og unngå å drikke vann fra ukjente kilder.
Reisebakterier kan føre til alvorlige sykdomsutbrudd på steder med dårlig hygiene, og derfor er riktig kunnskap om disse bakteriene viktig for å forstå hvordan man kan beskytte helsen på reise.
Forståelsen av reisebakterienes ulike egenskaper og overføringsmekanismer er avgjørende for utviklingen av effektive forebyggende strategier for å unngå ubehagelige helseproblemer på reisen.
Kunnskap om reisebakterier er viktig for alle reisende, enten de besøker et lokalt marked i en europeisk by eller et eksotisk reisemål i et tropisk klima.
Ved å ta forholdsregler og følge anbefalte råd for hygiene og matsikkerhet, kan reisende effektivt redusere risikoen for å bli smittet av disse farlige reisebakteriene.
Dette er viktig for å oppnå en positiv og problemfri reiseopplevelse for alle.
Reisebakteriers betydning for reiser og helse
Reisebakterier representerer en betydelig utfordring for reisende som ønsker å utforske verden uten å bli plaget av sykdom. Disse mikroskopiske organismene kan forårsake en rekke ubehagelige symptomer, fra milde magesmerter og diaré til alvorlige infeksjoner som krever medisinsk behandling.
Forståelsen av reisebakteriers varierte former og spredningsmekanismer er avgjørende for å minimere risikoen for sykdom på reisen. Ulike arter av reisebakterier har unike egenskaper og krav knyttet til reproduksjon og overlevelse.
En nøkkelfaktor er at disse bakteriene ofte kan overleve i mat og vann som ikke er tilstrekkelig behandlet eller lagret. Dette gjør det ekstra viktig å være oppmerksom på hygieniske forhold, spesielt når man inntar mat eller drikke fra uavhengige kilder under reisen.
Hygiene og riktig håndtering av matvarer spiller en avgjørende rolle i å beskytte seg mot reisebakterier. Kostholdsplaner og valgene man tar på restaurantbesøk og ved egen matlaging blir dermed svært viktige elementer for å begrense risikoen.
Reisebakteriers spredningsmekanismer varierer, og noen arter er mer sensitive for varmebehandling enn andre. Riktig koking og temperaturkontroll av matvarer er derfor avgjørende for å eliminere disse bakteriene. Reisende bør også være oppmerksomme på hvor maten kommer fra og hvordan den har blitt tilberedt.
Kunnskap om reisebakteriers potensiale for å forårsake sykdom er avgjørende for å forberede seg på reisen. Dette inkluderer å forstå hvilke matvarer og vannkilder som kan være farlige og å ha tilgang til aktuelle medisiner for å behandle symptomer dersom man blir syk.
Tilpasning av matvaner og hygienetiltak er derfor viktige strategier for å minimere risikoen for å bli smittet av reisebakterier på tur. Dette gjelder også når man velger å spise på lokale restauranter, og å være spesielt oppmerksom på rå eller ukokte matvarer.
Resistens hos reisebakterier
Reisebakterier, som ofte overføres via mat eller vann, kan utvikle resistens mot antibiotika, noe som representerer en alvorlig trussel mot folkehelsen.
Denne resistensen oppstår ved at bakteriene utvikler mekanismer for å unngå, redusere eller motstå virkningen av antibiotika.
En av de viktigste prosessene bak utviklingen av resistens hos reisebakterier er endringer i genene som koder for målproteinene som antibiotika virker på.
For eksempel kan reisebakterier utvikle mutasjoner i gener som koder for ribosomer, eller enzymer som bryter ned antibiotika, noe som gjør antibiotika ineffektive.
Disse genene for resistens kan overføres mellom forskjellige bakterieceller, og til og med mellom forskjellige arter av bakterier, via horisontal genoverføring.
Dette fenomenet gjør at resistens kan spre seg raskt og på en uforutsigbar måte, noe som kompliserer behandlingen av infeksjoner forårsaket av reisebakterier.
Resistensutvikling kan påvirkes av faktorer som antibiotikaanvendelse i husdyrhold, bruk av antibiotika i medisinsk behandling, og hyppigheten av infeksjoner med reisebakterier.
Overdreven bruk av antibiotika, både i mennesker og dyr, bidrar til utviklingen av resistens hos reisebakterier.
Hvis antibiotika blir brukt på en uansvarlig måte, vil det forsterke evolusjonen av resistente stammer. Dette betyr at fremtidige infeksjoner med reisebakterier kan bli mer kompliserte å behandle.
Det er viktig å forstå de komplekse mekanismene bak resistensutvikling for å utvikle effektive strategier for å forhindre spredning av resistente reisebakterier.
En bedre forståelse av disse mekanismene, inkludert faktorer som påvirker resistensutvikling, vil gi grunnlag for å utvikle bedre strategier for forebygging, infeksjonskontroll og behandling av infeksjoner forårsaket av resistente reisebakterier. Dette er av fundamental betydning for å sikre effektiv behandling av potensielt alvorlige infeksjoner.
Riktig og ansvarlig antibiotika bruk er avgjørende for å minimere utvikling av resistens hos reisebakterier, og for å opprettholde effektiviteten av tilgjengelige antibiotika over tid.
Forskning på mekanismene bak resistensutvikling, inkludert horisontal genoverføring, er derfor avgjørende for å utvikle nye strategier for å bekjempe denne utfordringen.
Effektiv overvåking av reisebakterier, inkludert deres evne til å utvikle resistens, er essensielt for å opprettholde effektiv behandling av infeksjoner forårsaket av disse bakteriene.
Reisebakterier: Resistensmekanismer og spredning
Den fjerde H2-faktor i forståelsen av reisebakterier handler om de ulike mekanismene bakteriene benytter for å utvikle resistens mot antibiotika og hvordan de sprer seg i miljøet og mellom mennesker.
Resistensutvikling er et alvorlig problem, ettersom det reduserer effektiviteten av antibiotikabehandling og kan føre til vanskelige eller uhelbredelige infeksjoner, særlig for reisende som kan eksponeres for nye bakteriestammer.
Reisebakterier kan utvikle resistens mot antibiotika gjennom flere mekanismer, som mutasjoner i gener som koder for målproteinene for antibiotika, endring i celleveggen eller produksjon av enzymer som bryter ned antibiotika.
Disse mekanismene kan overføres mellom bakteriestammer, inkludert reisebakterier, gjennom horisontal genoverføring, en prosess hvor gener blir overført fra en bakterie til en annen uten å være avledet fra foreldre-bakterien.
Det er også viktig å forstå hvordan reisebakterier sprer seg. Direkte kontakt med smittede personer, forurensning av mat og vann, og tilfeldig kontakt med infiserte overflater kan alle være bidragsytere til spredning. Særlig viktig er forståelsen av hvordan reisebakterier kan spre seg gjennom næringskjeder, noe som kan representere en særskilt risiko i områder med mangel på hygiene og sunne sanitærforhold.
Forståelsen av reisebakteriers resistensmekanismer og spredningsmønstre er avgjørende for å utvikle effektive strategier for å forebygge og behandle infeksjoner hos reisende. Dette inkluderer utvikling av nye antibiotika, forbedret hygiene, og bevisstgjøring om riktig bruk av antibiotika.
Kontroll av resistensutvikling og spredning av reisebakterier er et globalt helseproblem som krever samarbeid mellom forskere, helsemyndigheter og reisende selv. Forståelsen av disse faktorer er essensiell for å begrense risikoen for alvorlige infeksjoner og å fremme helse for reisende.
Reisebakterier representerer en betydelig utfordring for både reisende og helsevesenet, og deres betydning kan ikke overses.
Vi har sett hvordan ulike typer reisebakterier kan forårsake alvorlige sykdommer, fra milde magesmerter til livstruende infeksjoner, og at korrekt forståelse og forebygging er avgjørende.
Artikkelen har fremhevet viktigheten av å identifisere og forstå de forskjellige reisebakteriene som kan potensielt sette reisende i fare. Dette inkluderer forståelse av smittekilder, hvordan de spres, og de spesifikke sykdommene de kan forårsake.
Bekjempelse av reisebakterier krever en helhetlig tilnærming, fra forbedret hygiene og matsikkerhet på reisemål, til personlig proaktivitet hos reisende selv. Dette innebærer å velge mat og drikke med omhu, samt å oppsøke medisinsk hjelp ved mistenkt infeksjon.
Konsekvensene av ubehandlet infeksjon kan være alvorlige, og det er derfor avgjørende å ta reisebakterier alvorlig. Informasjon og forberedelser før en reise er avgjørende for å unngå potensielle helseproblemer, og reisebakterier er en viktig del av denne forberedelsen. Ved å forstå reisebakteriene, og å ta nødvendige forholdsregler, kan vi alle nyte reiseopplevelser med økt trygghet og bedre helse.